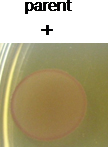
胞内糖原分析

往期刊物2014
卷册: 4, 期号: 11
生物化学
Small-scale Triton X-114 Extraction of Hydrophobic Proteins
Triton X-114法小规模提取疏水性蛋白
Protocol for Preparation of Nuclear Protein from Mouse Lungs
小鼠肺部细胞核蛋白制备法
Determination of Pseudokinase-ligand Interaction by a Fluorescence-based Thermal Shift Assay
荧光热变分析测定假激酶配体的相互作用
细胞生物学
Small-scale Subcellular Fractionation with Sucrose Step Gradient
蔗糖不连续密度梯度离心法进行小规模亚细胞分级分离
Novel Method for Site-specific Induction of Oxidative DNA Damage to Study Recruitment of Repair Proteins to Heterochromatin and Euchromatin
研究异染色体和常染色质修复蛋白补充的特定位点诱导DNA氧化损伤新方法
免疫学
Protocol for Macrophage Depletion from Mice
清除小鼠巨噬细胞的方法
In vitro Inflammasome Assay
体外炎性体试验
Identification of Helminth-induced Type 2 CD4+ T Cells and ILC2s
鉴定蠕虫诱导产生的2型 CD4+T细胞和第2组先天淋巴细胞(ILC2)的方法
微生物学
Preparation of Parasite Protein Extracts and Western Blot Analysis
寄生虫蛋白质提取物的制备和蛋白印迹分析
Intracellular Glycogen Assays
胞内糖原分析
Infant Rabbit Colonization Competition Assays
幼兔肠道中不同菌株的定植竞争分析
Immuno-EM Analysis of PF13_0191-GFP Expressing Parasites
PF13_0191-GFP 表达寄生虫的免疫透射电子显微分析
Purification and Structural Analysis of QS-inhibiting Compounds from Staphylococcus delphini
海豚葡萄球菌的QS抑制化合物的纯化和结构分析
干细胞
Competitive Bone-marrow Transplantations
竞争性骨髓移植